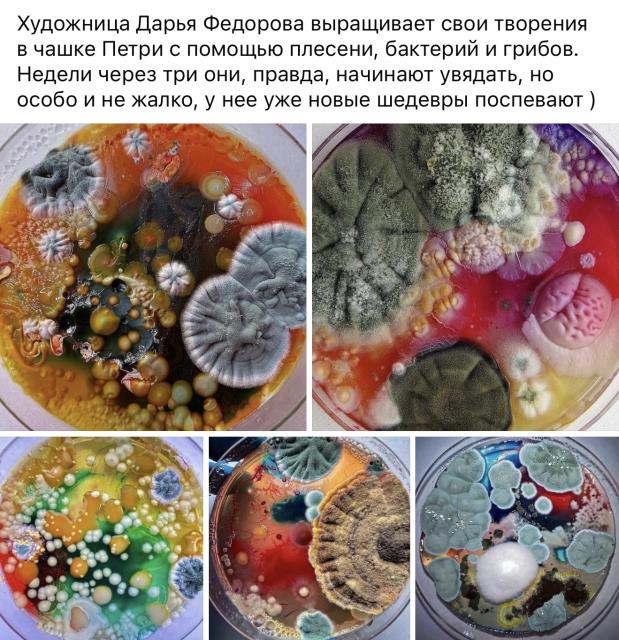

Раздел:
...затрудняюсь выбрать раздел
(Плесень)
В блог
Подписаться на Дзен!
Отвечать в конференциях и заводить новые темы может любой участник, независимо от наличия регистрации на сайте 7я.ру.
Искусство бывает разное
Вот попалось в ФБ. Тащу сюда.
Читаю там комментарии, большинство восторгается. А у меня рвотный рефлекс. То есть с одной стороны я могу найти в этом красоту, но с другой не могу, отталкивает меня плесень на еде, какая бы она красивая не была. Прям блок какой-то стоит. А у вас как? Красиво или фууу?
20.11.2024 23:01:42, KengaLu
46 комментариев
Красиво )
Красиво )
22.11.2024 11:39:44, Лягушка
Бррр →
Нет, для меня в этом нет красоты →
Нет, для меня в этом нет красоты. Неприятно смотреть и хочется отвернуться
Вдруг подумалось про рисунки Гигера. Вот их смотреть неприятно, но при этом не могу оторваться.
А с этой плесенью не так)
21.11.2024 20:52:31, Пилар, жена Пабло
представила, как это пахнет, бэээ
представила, как это пахнет, бэээ
21.11.2024 20:13:03, Света 2
Однозначно фууу.
Однозначно фууу.
21.11.2024 13:51:57, МумиМама123
Забавно получилось, разноцветно. Нет, мн →
Забавно получилось, разноцветно. Нет, мне не фу. Искусством это не считаю, так, поделки
21.11.2024 12:34:21, Чернобурка
все-таки "фу" Мозг говорит, что это →
все-таки "фу" Мозг говорит, что это красиво, а организм не согласен.
21.11.2024 11:41:20, Julinika
ВК есть группа "Мама, я вырастил →
ВК есть группа "Мама, я вырастил плесень"
Там выкладывают фото, у кого что случайно вырасло. Есть красивые варианты.
Предложеные фото мне не очень нравятся.
Недавно была на выставке про цветы в искусстрве и жизни, вот там была пара фотографий, как символ краткосрочной жизни цветов.
Мне понравились.

21.11.2024 10:00:24, Манюня Хнуш
Цвета красивые. Напоминает морскую →
Цвета красивые. Напоминает морскую разноцветную жизнь. Я не особо брезгливая, сейчас какого только «искусства» нет, это не самое противное:) Восторга тоже не испытываю, плесень и плесень..
21.11.2024 09:48:01, Спой, птичка!
Мне никак. Мне скорее «неоригинально →
Мне никак. Мне скорее «неоригинально неинтересно» чем «вау» или «фу»
21.11.2024 09:35:33, Natalya d'*
Хоть бы такое на нынешнем биеннале в →
Хоть бы такое на нынешнем биеннале в Венеции было ба((( А то спутанные нитки с привязанными к ним пучками волос. Вот у меня реально рвотный рефлекс был.
21.11.2024 09:22:06, Rujik
Сначала показалось красиво, а потом →
Сначала показалось красиво, а потом присмотрелась к серому мохнатому - и затошнило
21.11.2024 08:59:18, Наша мымра (ех. ПоЛе)
:-) Ну, то, что эти разноцветные →
:-) Ну, то, что эти разноцветные растворы - еда, неочевидно :-) Это может быть обычный питательный (для плесени) гель, лабораторная среда подкрашенная.
Мне - забавно. Не то, чтобы очень красиво, но уж точно не "фу". Хочется рассматривать, хорошо бы, чтобы были названия.... В общем, во мне просыпается любопытство при виде этого :-)
:-)) Но я и дома могу плесенью _любоваться_, если вдруг вырастет не обычная серо-зелёная или обычная чёрная, а какая-нибудь редкая розовая или сильно пушистая....
:-) Но я - дочь биолога и для меня восхищение витальностью окружающего мира (т.е. сила биологической жизни вокруг) - первично, а какая-то еда и тем более "чистота" (кому она нужна?) - вторичны :-)
21.11.2024 08:58:13, Неведома Зверушка
мне не нравится,искусством не считаю такое →
мне не нравится,искусством не считаю такое
21.11.2024 08:38:09, Морозулька
Когда я вспоминаю, что пенициллин →
Когда я вспоминаю, что пенициллин, полученный практически случайно и спасший миллионы и миллионы людей, включая моего отца и меня, по сути такая же плесень, да, для меня это прекрасно. Как художественное произведение параллельно, рвотный позыв не вызывает.
21.11.2024 08:27:19, Ша Нуар
Красоты в этом не вижу. Не фу и не →
Красоты в этом не вижу. Не фу и не отвращение (по крайней мере по фото), но не красота и не искусство.
21.11.2024 08:20:50, Ящер
Ну такое себе. В мое понятие прекрасного →
Ну такое себе. В мое понятие прекрасного не попадает:)
21.11.2024 08:19:01, IrenAr
Плесень - это и есть грибы :) Я →
Плесень - это и есть грибы :)
Я нормально воспринимаю, сама иногда восхищаюсь тому, что может вырасти в позабытой баночке творожного сыра в холодильнике.
Стандартный опыт для студентов в начале курса Микробиологии: открываешь чашки Петри с питательным субстратом на несколько секунд в разных помещениях, через неделю смотришь, что выросло. Тоже красиво получается :) Из туалета меньше вырастает, кстати (что объяснимо, если подумать). Так что мы всем этим дышим и носим на себе. Такой вот невидимый мир.
21.11.2024 08:09:13, Dots
так она поди не на еде. раз в чашке →
так она поди не на еде. раз в чашке петри, а не в чашке супа
21.11.2024 05:14:37, Коза Агата
В чашку Петри можно ведь положить что угодно. На фотках я вижу еду под плесенью. Я фотки открывала посмотреть
21.11.2024 05:23:47, KengaLu
Там не еда, субстрат типа холодца. Цвет дают сами микроорганизмы
21.11.2024 08:11:20, Dots
я еду не углядела. так-то много что еда из исследуемого в чашках - продукты же тоже так проверяют перед тем, как пускать к потребителям (это я статью пишу про микробиолога молочного завода, она как раз свои сыр, масло и тп исследует)
21.11.2024 06:54:10, Коза Агата
Конечно. Вопрос в другом. Красиво вам такое искусство или фу?
21.11.2024 07:16:58, KengaLu
да, я ушла далеко от темы :) фото симпатичные. фу не вызвало, восторга тоже. скорее, удивительна мне не красота, а умение именно вот так вырастить
еще раз отвлекусь - сестра в школьные годы раз для урока выращивала плесень.кусок хлеба намочила и на шкаф убрала. через несколько дней какая ж красота выросла там! и вот эта как мох, и длинные высокие какие-то, с синевой :) не такие конечно как тут, но тоже интересные
21.11.2024 07:20:03, Коза Агата
Брр
Гадость какая! →
Не стОит ругать плесень Хотя бы за →

Не стОит ругать плесень
Хотя бы за наличие антибиотиков первых. А то так бы и продолжали умирать без пенициллина
«Благородная плесень» Botrytis cinerea, поражающая ягоды винограда прямо на лозе, необходима для изготовления сотерна и некоторых других вин. Ряд видов грибка пеницилла — Penicillium roqueforti, P. camambertii и P. caseicolum — создают знаменитые сыры: рокфор, горгонцолу, стилтон, камамбер, бри, дор-блю и др.
Грибки рода Mucor (в том числе белая плесень) и близких к нему родов входят в состав так называемых китайских дрожжей, широко употребляемых в дальневосточной кухне, в частности для производства тофу.
Грибок Aspergillus oryzae используется в Японии для приготовления соевого соуса и саке, а его близкий родственник A. niger применяется для промышленного производства лимонной кислоты.
Но самый ценный подарок плесени человечеству — антибиотики. Именно из пеницилла был выделен первый препарат этой группы — пенициллин. И в наши дни часть антибиотиков получают из различных видов плесневых грибков.
21.11.2024 00:26:11, Степная кошка
Не ругаю плесень. Спрашиваю кому красиво а кому фу. Прямой вопрос
21.11.2024 01:05:05, KengaLu
никакого фу у меня нет. Вполне себе фото в лабораторной посуде между прочим, как раз для всякого такого и предназначенной Вреда от нее нет, на людей она не нападает, по квартире не бегает, не гадит, не шумит
21.11.2024 01:08:04, Степная кошка
Достаточно «мне красиво» :)
21.11.2024 01:14:10, KengaLu
мне никак Отвращения не вызывает, восторга тоже
21.11.2024 01:22:18, Степная кошка
Я поняла. Спасибо
21.11.2024 01:27:30, KengaLu
Не понять нам эту красоту , не доросли ещё ))
Не понять нам эту красоту , не доросли ещё ))
20.11.2024 23:52:34, Ежик 1
Мне недавно рассказали пример из курса →
Мне недавно рассказали пример из курса этики: люди по-разному относятся к разным биологическим видам. Готовы спасать китов и краснокнижных лягушек, при этом нещадно истребляют плесень и некоторые виды бактерий.
20.11.2024 23:34:46, starka
Ну это понятно и не удивительно.
Вот кстати вспомнила что фотографии ржавчины мне попадались очень красивые, залюбуешься. А кому то видимо плесень так
20.11.2024 23:40:23, KengaLu
Фу. Плесень она и есть плесень, хоть и →
Сказано красиво. Бактерии невидимы →
Сказано красиво. Бактерии невидимы, вроде. А плесень - грибы и есть..
20.11.2024 23:24:29, Funny Rain
Ой, ну нет. Это хочется выбросить, все →
Ой, ну нет. Это хочется выбросить, все отмыть и продезинфицировать. И забыть как страшный сон ))
подозреваю, что биологи могут в этом найти красоту. Им, наверное, каждая плесенюшка из этих "картин" знакома :))
20.11.2024 23:19:48, УникаЛьнаЯ
Вот вот! Мне даже отмывать не хочется, а выбросить вместе с посудой :))) но воздух вокруг побрызгать какой нибудь хлорированной химией :)
20.11.2024 23:23:50, KengaLu
отмывать то, где эти чашки стояли. Их выбросить, однозначно
21.11.2024 08:07:49, УникаЛьнаЯ
У меня фу. →
У меня фу.
20.11.2024 23:07:34, Mary M.
Наверное, этим надо под веществами любоваться.. →
Наверное, этим надо под веществами любоваться..
20.11.2024 23:06:35, Беата (просто читатель)
:))) я заглянула в профили некоторых кто восхищается. Возраст солидный. Не выглядят как употребляющие. :)
20.11.2024 23:11:52, KengaLu
А может flashback с того времени когда употребляли :)))
21.11.2024 01:28:11, KengaLu
Читайте также
Татьянин день: традиции, приметы и студенческие ритуалы удачи
Татьянин день издавна считался особой датой: по погоде 25 января судили о весне и урожае, а студенты верили, что в этот день можно договориться с удачей. Народные приметы, университетские суеверия и традиции, которые до сих пор живут в студенческой среде.